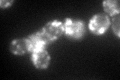
YIL076W
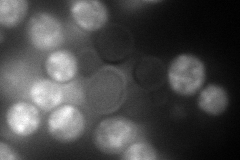
YIL076W
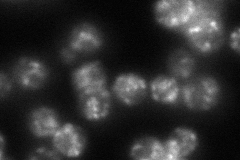
YIL076W
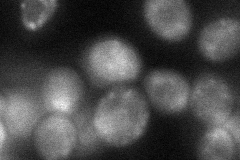
YIL076W
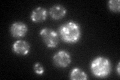
YIL076W

View description
Epsilon-COP subunit of the coatomer; regulates retrograde Golgi-to-ER protein traffic; stabilizes Cop1p, the alpha-COP and the coatomer complex; non-essential for cell growth
Localization:
Intensity:
Fold change:
Significance:
-
C’ GFP library in SD
punctate89.88 -
N' NOP1pr-GFP in SD

punctate175.44 -
N' TEF2pr-mCherry in SD
cytosol,punctate121.9 -
N' NATIVEpr-GFP in SD
punctate59.6029 -
N' TEF2pr-VC and Cyto-VN in SD
cytosol,punctate49.6366 -
C’ GFP library in SD+DTT

punctate123.391.37Yes -
C’ GFP library in SD+H2O2

punctate87.890.97No -
C’ GFP library in Starvation Media
punctate97.241.08No -
C’ GFP library on the background of Pup2-DaMP

punctate -
C’ GFP library on the background of CCT mutant

punctate79.86210.888432No
